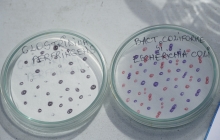

Ziua Mondială a Apei 2026 -Târgu Lăpuș

Plată factură online

Contracte online

Acte contract

Tarife apă și canalizare

Tur virtual stație tratare apă

Întreruperi furnizare apă

Media